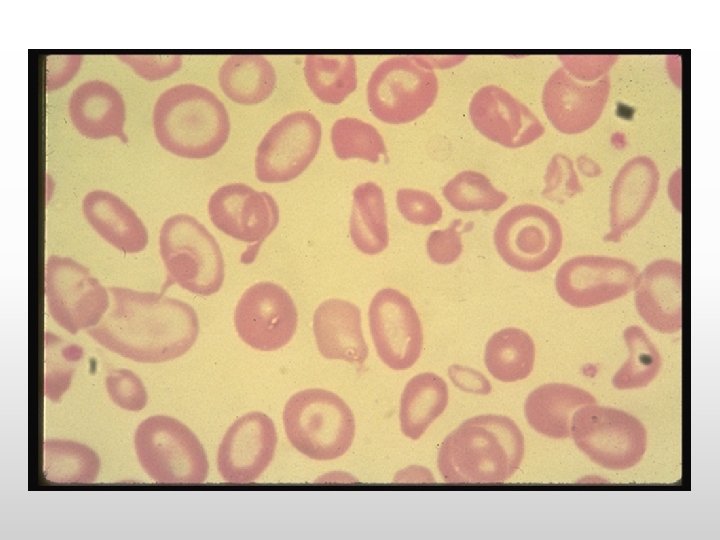

Thalassemia Syndromes Thalassemias are geneticAR disorders in globin

Thalassemia Syndromes Thalassemias: are genetic(AR) disorders in globin chain production.

In individuals with β-thalassemia, there is either: complete absence of β-globin gene production -thalassemia) or partial reduction (β+-thalassemia) β-thalassemias can be classified clinically as thalassemia trait thalassemia minima thalassemia minor thalassemia intermedia thalassemia major (β 0

HOMOZYGOUS β-THALASSEMIA (THALASSEMIA MAJOR) (COOLEY'S ANEMIA)

pathogenesis of β-thalassemia: 1. Reduction of β-chain synthesis. 2. Relative α-globin chain excess resulting in intracellular precipitation of insoluble α-chains. 3. Increased but ineffective erythropoiesis with many red cell precursors prematurely destroyed; related to α-chain excess. The γ-globin chains are produced in increased amounts, leading to an elevated Hb F (α 2γ 2). The δ-globin chains are also produced in increased amounts, leading to an elevated Hb. A 2(α 2δ 2) in β-thalassemia. 4. Shortened red cell life span; variable splenic trapping.

Sequelae 1. Hyperplastic marrow (bone marrow expansion with cortical thinning and bony abnormalities). 2. Increased iron absorption and iron overload (especially with repeated blood transfusion), resulting in: • Fibrosis/cirrhosis of the liver • Endocrine disturbances (e. g. , diabetes mellitus, hypothyroidism, hypogonadism, hypoparathyroidism, hypopituitrism) • Skin hyperpigmentation • Cardiac hemochromatosis causing arrhythmias and cardiac failure. 3. Hypersplenism: • Plasma volume expansion • Shortened red cell life. • Leukopenia • Thrombocytopenia.

Clinical Features Clinical manifestations of beta thalassemia major include: • Failure to thrive in early childhood • Anemia • Jaundice, usually slight; gallstones • Hepatosplenomegaly, which may be massive; hypersplenism • Bone abnormalities: • Abnormal facies, prominence of malar eminences, frontal bossing, depression of bridge of the nose and exposure of upper central teeth • Skull radiographs showing hair-on-end appearance due to widening of diploic spaces • Fractures due to marrow expansion and abnormal bone structure • Generalized skeletal osteoporosis. • Growth retardation, delayed puberty, primary amenorrhea in females and other endocrine disturbances secondary to chronic anemia and iron overload • Leg ulcers • Skin bronzing.

Complications develop as a result of: 1. Chronic anemia (in patients who are undertransfused ) 2. Iron overload – Due to repeated red cell transfusions in β-thalassemia major. Even in carefully managed patients, the following complications may develop: a. Endocrine disturbances (e. g. , growth retardation, pituitary failure with impaired gonadotropins, hypogonadism, insulin-dependent diabetes mellitus, adrenal insufficiency, hypothyroidism, hypoparathyroidism) b. Cirrhosis of the liver and liver failure (exacerbated if concomitant hepatitis B or C infection is present) c. Cardiac failure due to myocardial iron overload (often associated with arrhythmias and pericarditis may occur) d. Osteopenia and osteoporosis

Causes of Death 1. Congestive heart failure. 2. Arrhythmia. 3. Sepsis secondary to increased susceptibility to infection post-splenectomy. 4. Multiple organ failure due to hemochromatosis.

LABORATORY FINDINGS Hematology 1. Anemia – hypochromic, microcytic. 2. Reticulocytosis. 3. Leukopenia and thrombocytopenia (may develop with hypersplenism). 4. Blood smear – target cells and nucleated red cells, extreme anisocytosis, contracted red cells, polychromasia, punctate basophilia, circulating normoblasts. 5. Bone marrow – may be megaloblastic (due to folate depletion); erythroid hyperplasia. 6. Serum ferritin – raised.

7. Haemoglobin Electrophoresis • In homozygous β 0 thalassaemia: Hb F accounts for up to 98 % of the total. • In double heterozygous β+ thalassaemia: Hb F accounts for 40 -60 % • Hb A 2 is increased in both defects.

Biochemistry 1. Raised bilirubin (chiefly indirect). 2. Evidence of liver dysfunction (late, as cirrhosis develops). 3. Evidence of endocrine abnormalities (e. g. , diabetes , hypogonadism [low estrogen and testosterone], hypothyroidism [elevated thyroid stimulating hormone]).

Management: lines of treatments includs: Transfusion Therapy Splenectomy Bone marrow transplantation Transfusion Therapy A transfusion program generally requires monthly transfusions, with the pretransfusion hemoglobin level >9. 5 and <10. 5 g/d. L. In patients with cardiac disease, higher pretransfusion hemoglobin levels may be beneficial. Typical programs involve transfusion of 10– 15 cc/kg of packed leukodepleted red cells. Post-transfusion hemoglobin falls roughly 1 g per week, necessitating transfusions every 3– 4 weeks.

Transfusions result in: • Maximizing growth and development • Minimizing extramedullary hematopoiesis and decreasing facial and skeletal abnormalities • Reducing excessive iron absorption from gut • Retarding the development of splenomegaly and hypersplenism by reducing the number of red cells containing α-chain precipitates that reach the spleen • Reducing and/or delaying the onset of complications (e. g: cardiac) Iron overload results from: • Ongoing transfusion therapy • Increased gut absorption of iron. Chelation Therapy Indications for chelation therapy in patients receiving chronic transfusions include: • Cumulative transfusion load of 120 ml/kg or greater • Serum ferritin level more than 1, 000 ng/ml

Deferoxamine (Desferal): it chelates iron allowing its excretion in urine and stool. Deferoxamine is given subcutaneously over 10– 12 hr, 5 – 6 days a week. The number of hours deferoxamine is used daily is more important than the daily dose. High-dose, short-term infusions increase toxicity with little efficacy. Nightly subcutaneous administration of deferoxamine is timeconsuming and painful and interferes in many ways with the lifestyle of the patient. Side effects include ototoxicity with high-frequency hearing loss, retinal changes, and bone dysplasia with truncal shortening.

Two oral chelators: Deferasirox (Exjade) is supplied as orally tablets, which are dissolved in a glass of water or juice and administered 1/2 hour before meals. Deferiprone for children >2 yr of age. Deferiprone may not be as effective as deferoxamine in total body iron chelation, but may be more effective in removing cardiac iron. Side effects include neutropenia, so weekly blood counts are needed.

Splenectomy is avoided if possible due to the risk of infection. Indications for splenectomy include: • Persistent increase in blood transfusion requirements by 50% or more over initial needs for over 6 months • packed red cell transfusion requirements in excess of 250 ml/kg/year in the face of uncontrolled iron overload (ferritin greater than 1, 500 ng/ml or increased hepatic iron concentration) • Evidence of severe leukopenia and/or thrombocytopenia.

* At least 2 weeks prior to splenectomy, a polyvalent pneumococcal and meningococcal vaccine should be given. If the patient has not received a Haemophilus influenza vaccine, this should also be given. Following splenectomy, prophylactic penicillin 250 mg bid is given to reduce the risk of overwhelming postsplenectomy infection.

Supportive Care 1. Hepatitis A and B vaccination should be given to all patients. 2. Folic acid is not necessary in hypertransfused patients; 1 mg daily orally is given to patients on low transfusion regimens. Bone marrow transplantation : All children who have an HLA-matched sibling should be offered the option of bone marrow transplantation. Gene Therapy

Thalassemia trait is frequently misdiagnosed as iron deficiency in children. A short course of iron and re-evaluation is all that is required to identify children who will need further evaluation. on hemoglobin analysis, they have elevated Hb F and Hb A 2. Haemoglobin Electrophoresis: Hb F Hb A 2 Hb A (2 – 6% ) ( 3 - 7 %) (87 - 95 %)

α-THALASSEMIA


In In α-thalassemia, there are relatively fewer α-globin chains and an excess of β- and γ-globin chains. These excess chains form Bart's hemoglobin (γ 4) in fetal life and Hb H (β 4) after birth. These abnormal tetramers are not as lethal, but lead to extravascular hemolysis. Prenatally, a fetus with α-thalassemia may become symptomatic because Hb F requires sufficient α-globin gene production, whereas postnatally, infants with βthalassemia become symptomatic because Hb A requires adequate production of β-globin genes. Infants are identified in the newborn period by the increased production of Bart's hemoglobin (γ 4) during fetal life and its presence at birth.

There are four α-globin genes and four deletional αthalassemia phenotypes: The deletion of 1 α-globin gene (silent trait) is not identifiable hematologically. No alterations are noted in the mean corpuscular volume and mean corpuscular hemoglobin. During the newborn period, typically <3% Bart's hemoglobin is observed.

2 α-globin genes results in α-thalassemia trait. The deletion of The globin genes can be lost in trans ( -α/-α), or in cis ( α, α/-- ). The α-thalassemia traits present as a microcytic anemia that can be mistaken for iron-deficiency anemia. The hemoglobin analysis is normal, except during the newborn period, when Bart's hemoglobin is commonly <8%, but >3%. The simplest way to distinguish between iron deficiency and αthalassemia trait is with a good dietary history. Children with irondeficiency anemia often have a diet that is low in iron. Alternatively, a brief course of iron supplementation, along with monitoring of the red blood cell parameters, may make the diagnosis of iron deficiency.

The deletion of 3 α-globin genes leads to the diagnosis of Hb H disease. The simplest manner of diagnosing Hb H disease is during the newborn period, when the Bart's hemoglobin level is commonly >25%. In addition, supporting evidence must be obtained from the parents (at least 1 parent must have α-thalassemia trait). Later in childhood, there is an excess of β-globin chain tetramers that results in Hb H. A definitive diagnosis of Hb H disease requires DNA analysis. Individuals with Hb H disease have marked microcytosis, anemia, mild splenomegaly, and occasionally, scleral icterus or cholelithiasis. Transfusion is not commonly used for therapy because the range of hemoglobin is 7. 0– 11. 0 g/d. L.

The deletion of all 4 α-globin genes causes profound anemia during fetal life, resulting in hydrops fetalis. There are no normal hemoglobins present at birth (primarily Bart's hemoglobin, with Gower-1, Gower-2, and Portland). If the fetus survives, immediate exchange transfusion is indicated. These infants with α- thalassemia major are transfusion-dependent, and bone marrow transplant is the only cure. Treatment -folate supplementation, - possible splenectomy (with the attendant risks), -intermittent transfusion during severe anemia, and chronic transfusion therapy or bone marrow transplant for survivors of hydrops fetalis. -These children also should not be exposed to oxidant medications.
- Slides: 27